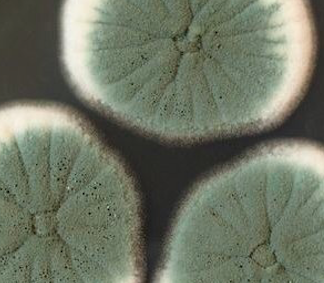
Podredumbre azul por hongos

Por qué no debes comer una manzana a medio pudrir o demasiado madura
Un consumo reiterado de fruta pocha puede afectar a varios órganos, como riñones e hígado
Es algo que muchos hacemos: comernos una manzana aunque ya haya empezado a deteriorarse, para lo cual desechamos la parte pocha, excesivamente madura o podrida. Pues bien, no es una buena idea.
Aunque se descarte la parte más fea, el consumo continuado de este tipo de alimentos puede provocar daños. No ocurrre nada por hacerlo puntualmente, pero sí puede acabar siendo un problema si se convierte en una práctica habitual, tal como ponen de relieve expertos en microbiología como Jéssica Gil Serna (@jessigserna), profesora en la Universidad Complutense de Madrid.
“Una exposición crónica puede afectar gravemente a distintos órganos”, escribe en su cuenta de twitter esta experta. "Los afectados serían fundamentalmente los riñones y el hígado", y ello se debe a que la podredumbre la produce una toxina genotóxica, lo que significa que “puede dañar el ADN de nuestras células”, tal como recoge en un artículo el Huffington Post.
Si el consumo de fruta pocha no es habitual, no debería representar ningún problema para la salud, admite Jessi Gil Serna en las explicaciones y respuestas en el hilo de twitter en el que aclara estas cuestiones. "De hecho, tampoco lo hay con los productos derivados como zumos, compotas o purés, que suelen hacerse con manzanas que no están perfectas al recogerse", señala al respecto.
La responsable de la podredumbre es la patulina, una micotoxina que produce un hongo, cuyos efectos se observan si la fruta tiene una podredumbre azul, que se difunde por la manzana mucho más allá de la zona de la lesión. Por eso no basta sólo con quitar la zona pocha para librarse de su acción.
¿Se pueden comer peras o uvas ya pochas?
La pochedumbre no es exclusiva de la manzana, sino que también está presente en otras frutas como peras, uvas, nectarinas y todos sus derivados. De ahí que la microbióloga insista en que es importante extender la recomendación de la manzana a otras piezas del frutero.
Eso sí, la experta advierte de que hay que ser más estrictos con los niños, ya que “son muy susceptibles a los efectos tóxicos de la patulina”, quien no obstante lanza un mensaje de tranquilidad al segurar que "no hay peligro en los productos derivados para bebés ya que la legislación es especialmente restrictiva" en estos casos.